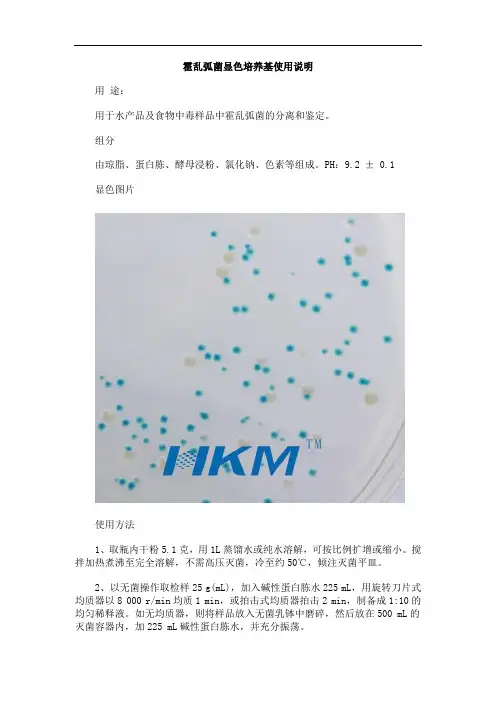

霍乱弧菌的分离与鉴定
- 格式:doc
- 大小:227.50 KB
- 文档页数:16


霍乱弧菌检验程序一、检查对象一天内腹泻三次或三次以上的病人。
二、标本采集及处理1、采集时间:在未服用抗生素前采样。
2、采集方式:用棉拭子或采便管从肛门插入直肠3—5厘米取样,必须看到有粪便黏附才可:对于自然排出的水样便、呕吐物及保存液保存的标本可直接接种分离或吸取0.5ML、成形大便取黄豆左右大小。
3、标本送检:标本采集后应立即送检。
若不能立即送检,可保存于碱性蛋白胨水中尽快送检验。
24小时以上才能送检的标本,应使用文一腊二氏保存液保存。
4、标本处理:将标本直接分离接种于4号琼脂及放入8—10ML碱性蛋白胨水中增菌。
“两管三板”:送检标本马上接种一个4号琼脂平板、同时碱性蛋白胨水培养管增菌;—8小时后接种增菌管内标本于第二块4号琼脂平板,同时转种第二管碱性蛋白胨水;6—8小时后继续接种第二管碱性蛋白胨水的标本于第三块4号琼脂平板上。
三、检验程序:1、弧菌形态:弧菌生长快、菌落大、培养4—5小时,原划线处有菌苔生长,8—10小时可长出小菌落,16小时菌落直径可达2毫米。
菌落略带灰色、半透明、扁平、稍隆起、光滑湿润,培养时间延长或室温放置后,菌落略带黄色,中心厚而周围透明,培养基含亚碲酸钾使得菌落成灰色,中心形成黑色金属碲沉淀。
在平皿上挑取典型菌落做玻片凝集试验。
2、玻片凝集试验:首先要注意抗原抗体比例和保证抗原(菌株)的纯洁性,使用O1群和O139群两种诊断血清。
如未获单个菌落,可挑取可疑菌苔边缘透明部分做玻片凝集。
注意,凝集的菌落应以生理盐水作对照,检查有无自然凝集;然后用此玻片显微镜下看动力(动力活泼如流星样);再将此玻片革兰氏染色看弧菌形态。
3、弧菌分型:稻叶型和小川型诊断血清做玻片凝集试验进一步分型。
四、报疫程序:一旦发现阳性可疑标本立即用铁罐保存,通知送检科室,确认病人资料;上报医院总值班2460或2560,派车送海珠区防疫站确证。
五、标本处理:发现Ⅱ号菌阳性可疑标本,即送标本往防疫站确认。

霍乱常⽤的实验室检查有:
(1)直接镜检:
①直接涂⽚染⾊:将标本涂⽚,固定后⽤1∶10稀释⽯炭酸复红染⾊和⾰兰⽒染⾊,镜检有⽆典型弧菌。
典型霍乱弧菌互相连接平⾏排列,有如“鱼群”。
②悬滴标本:将标本制成悬滴,镜检细菌动⼒,⽤暗视野显微镜。
霍乱弧菌运动活泼,呈⼩鱼穿梭状。
(2)分离培养:将吐泻物直接或先经碱性胨⽔增菌后,接种于庆⼤霉素琼脂等培养基,容易检出霍乱弧菌。
应⽤荧光抗体检测粪便中霍乱弧菌,可于1~2⼩时内获得结果。
(3)⾎清学检查:可作⾎清凝集试验。
在发病第1~3⽇及第10~15⽇各取1份⾎清,若第2份⾎清的抗体效价⽐第1份增⾼4倍或4倍以上,有诊断参考价值。
(4)制动试验——快速诊断:在急性病⼈的⽔样便中含有⼤量弧菌,如悬滴检查阳性,再滴加不含防腐剂的霍乱多价⾎清(使⽤浓度为1∶64),⼏分钟内细菌运动停⽌,凝集成块即为阳性。
若具备下列条件之⼀者,可确诊为霍乱:
①凡有腹泻、呕吐等症状,⼤便培养霍乱弧菌阳性者;
②霍乱流⾏期间,在疫区有典型霍乱症状,⼤便培养阴性,⽽⽆其他原因可查者;
③有吐泻症状,霍乱弧菌培养阴性,作⾎清凝集试验第2份⾎清抗体效价呈4倍以上增⾼者。
在⾮疫区,凡有典型泻吐症状,在病原学检查未确定时,或在霍乱流⾏期间,曾接触过霍乱患者,有腹泻症状⽽⽆其他原因可查者,均应⾼度怀疑为霍乱,在给予积极处理的同时,应作⼤便培养,隔⽇1次,连续3次阴性者,才可以否定诊断,并作出疫情更正报告。

![[医药卫生]霍乱弧菌实验室检验技术](https://uimg.taocdn.com/a6fba859ddccda38366baf17.webp)



霍乱弧菌的分离与鉴定濮阳市疾病预防控制中心一、标本的采集和送检:1.标本的采集:1)粪便标本:应争取在发病早期、服用抗菌药物之前采集;2)采便方法:可用棉拭采取自然排出的新鲜大便,亦可用直肠棉拭采便管由肛门插入直肠内3~5厘米处采取。
3)采样要求:☞水样便采取1~2毫升,成形便采取指甲大小的粪量。
病人呕吐物、沾染粪便的衣物、尸体的肠腔和口腔内容物亦可作为检材。
☞外环境样本可采取病人的污染衣物、剩饭菜、可疑食品、抹布、污水、坑塘水、井水、公厕粪便、苍蝇等。
☞按1:10比例置入碱性蛋白胨水增菌液中,迅速送往实验室。
4)肛拭采集的注意事项:1.棉拭子要用竹签,圆形、光滑以免采样时易断;2.棉拭子做的要稍大而紧固(避免采集时脱落);3.采集者应穿戴一次性手套;4.采集前将棉拭子用碱性蛋白胨水(APW)蘸湿,多余的液体紧靠管壁挤出;5.采集时要求被采集者双腿分立、微屈、手扶墙或凳子趴下,劝其用单手或双手协助分开股沟(或采集者用左手分开股沟),右手持棉拭子轻轻旋转插入肛门内约4~5cm(幼儿约2~3cm)处,转动数秒钟从紧靠肛环边的隐窝旋转擦取直肠表面黏液后退出;6.棉拭子在推进时如感觉遇到阻力,应调整角度后缓缓旋转推进,避免用力过大或推进太快造成肛壁出血而影响病原菌的检出;棉拭子进入的深度一定要够,否则采集的有效标本量会很少;7.采集的标本拭子应立即置入APW内,手接触的部分在管口折断弃去。
填写采样登记表(单),并在采样管上填写被采集者的样品编号、姓名、性别、年龄,尽快送检。
二、快速诊断:1.直接镜检:为争取最快速度作出诊断,采取病人“米泔水样”大便或呕吐物,悬滴法镜检(最好用暗视野),可见具有流星状动力的细菌。
2.特异性制动试验:☞取检材或新鲜碱性蛋白胨水培养物一滴,置于载玻片上,再加霍乱弧菌O1多价或O139诊断血清,加盖玻片,用暗视野显微镜观察,3分钟内流行状运动细菌被抑制的即为阳性,此法优点是快速而特异,操作简便,可☞在几分钟之内做出初步诊断。

野生水鸟感染霍乱弧菌和沙门菌等病原菌的分离和鉴定祝令伟;郭学军;景洁;梁冰;王莹;田园;纪雪;孙洋;初冬;高玉伟【摘要】目的从死亡的野生水鸟标本中分离、鉴定病原菌,评估迁徙鸟类传播人兽共患病原菌的风险.方法采集的组织标本涂布营养琼脂平板,分别在需氧和厌氧的条件下培养.分离的菌株使用Phoenix100全自动微生物鉴定仪和16srRNA测序的方法鉴定细菌种属,随后通过PCR的方法检测病原菌携带主要毒力基因的情况.结果从骨顶鸡、鸬鹚和红嘴鸥等鸟类的组织标本中分离鉴定出霍乱弧菌、沙门菌和产气荚膜梭菌等多种肠道感染相关的病原细菌.霍乱弧菌经PCR鉴定不属于O1和O139血清群,无霍乱毒素和毒素相关菌毛的编码基因,但是有溶血素的编码基因.结论检测的死亡鸟类个体存在多病原细菌的感染.【期刊名称】《中国人兽共患病学报》【年(卷),期】2019(035)003【总页数】5页(P212-215,222)【关键词】野生鸟类;霍乱弧菌;沙门菌;风险评估【作者】祝令伟;郭学军;景洁;梁冰;王莹;田园;纪雪;孙洋;初冬;高玉伟【作者单位】军事科学院军事医学研究院军事兽医研究所/吉林省人兽共患病预防与控制重点实验室,长春 130122;军事科学院军事医学研究院军事兽医研究所/吉林省人兽共患病预防与控制重点实验室,长春 130122;军事科学院军事医学研究院军事兽医研究所/吉林省人兽共患病预防与控制重点实验室,长春 130122;军事科学院军事医学研究院军事兽医研究所/吉林省人兽共患病预防与控制重点实验室,长春130122;军事科学院军事医学研究院军事兽医研究所/吉林省人兽共患病预防与控制重点实验室,长春 130122;军事科学院军事医学研究院军事兽医研究所/吉林省人兽共患病预防与控制重点实验室,长春 130122;军事科学院军事医学研究院军事兽医研究所/吉林省人兽共患病预防与控制重点实验室,长春 130122;军事科学院军事医学研究院军事兽医研究所/吉林省人兽共患病预防与控制重点实验室,长春130122;国家林业和草原局森防总站,沈阳 110000;军事科学院军事医学研究院军事兽医研究所/吉林省人兽共患病预防与控制重点实验室,长春 130122【正文语种】中文【中图分类】R378野生动物被认为是“病原的天然储存库”,许多烈性的人类传染病如SARS和埃博拉等,其感染和传播的源头都指向野生动物。
霍乱弧菌的检验程序临床细菌实验室接到高度疑似患者标本,应尽快地进行检验。
具体处理方法如下。
1.临床标本(患者排泄物、呕吐物、肛拭、肛管内容物及残留、剩余食物等)直接涂片,观察动力,再做制动试验以及革兰染色,镜检发现革兰阴性、细小、直的、微弯、逗号状的杆菌。
疑似者即予电话报告2.标本直接接种:①血琼脂平板;②弧菌鉴别性平板(4号琼脂平板、碱性琼脂平板);③接种碱性胨水3.保留原始标本(不可置于冰箱冷藏)4.35℃孵育上述所有平板及胨水5.6~8h后:①取碱性胨水培养物涂片(直接观察动力、做制动试验)染色镜检;②移种鉴别性琼脂平板和血琼脂平板;③霍乱红试验;④观察血琼脂平板,见有微小菌落生长。
立即涂片染色,霍乱多价血清凝集,氧化酶试验。
如符合霍乱弧菌的推断性鉴定,可作出早期初步报告。
6.继续孵育过夜后,做玻片凝集试验。
自分离平板上挑取可疑菌落与霍乱多价诊断血清做玻片凝集试验,所用血清的效价应在1:80~1:160,如过浓,则稀释后再做凝集。
将稀释血清滴加在洁净的载玻片上,挑取可疑菌落混悬于血清内,即刻(一般不超过10s)出现肉眼可见的明显凝集者为阳性。
菌落应以生理盐水作对照,不发生凝集。
为了提高阳性检出率,应多挑可疑菌落进行玻片凝集。
将O1群霍乱多价血清凝集阳性菌落再做氧化酶、涂片染色镜检,初步推断性鉴定,将此高度疑似菌株,报告当地疾病控制中心做最后鉴定。
霍乱弧菌的检测1.涂片检查:取新鲜送检标本涂片2张,干燥后,用乙醇或甲醇固定,分别用革兰染色剂1:10稀释的石碳酸复红染色,用油镜检查,观察有无革兰阴性呈鱼群排列的弧菌。
悬滴检查:取患者粪便,制成悬滴标本或圧滴标本,检查细菌的动力,霍乱弧菌古典型和EL-Tor型常呈穿梭状及活泼的活动,在悬滴涂片中加O1群霍乱弧菌诊断血清后,在显微镜下观察,若原运动活泼的现象停止,为制动试验阳性。
2.培养:取疑似患者粪便直接接种于碱性蛋白胨水中,进行增菌,同时划线接种于碱性琼脂平板或TCBS平板及血液琼脂平板,孵育于35℃。
台湾泥鳅腐皮病霍乱弧菌的分离与鉴定杨宁;姜芳燕;陈攀;马军;陈燕;曹柳;侯兴蓉【期刊名称】《海南热带海洋学院学报》【年(卷),期】2024(31)2【摘要】为研究台湾泥鳅(Paramisgumus dabryanus ssp.)腐皮病的病原,对其腐皮等病变部位进行细菌分离纯化,获得1株优势菌株,命名为P1,利用革兰氏染色观察其形态特征,利用PCR扩增技术、16S rRNA基因测序,得到病原菌的序列,用MEGA软件构建系统进化树,再结合生理生化分析结果鉴定菌种名称。
结果发现:革兰氏染色阴性,弧形,两端钝圆;菌体长1~1.5μm,宽度1~1.2μm,有菌丝和鞭毛,16S rRNA基因1 395 bp。
建立系统进化树后发现,P1与霍乱弧菌处于同一分支;生理生化实验结果与霍乱弧菌一致,从而鉴定该菌株为霍乱弧菌(Vibrio cholerae)。
药敏实验结果表明,该分离菌株对头孢哌酮、卡那霉菌、万古霉素等10种抗生素高度敏感;对四环素中度敏感;对呋喃唑酮、复方新诺明、克林霉素等17种抗生素耐药。
实验结果为台湾泥鳅腐皮病的病原鉴定与药物防治提供参考。
【总页数】7页(P18-24)【作者】杨宁;姜芳燕;陈攀;马军;陈燕;曹柳;侯兴蓉【作者单位】海南热带海洋学院热带海洋生物资源利用与保护教育部重点实验室;海南热带海洋学院海南省热带海洋渔业资源保护与利用重点实验室;海南热带海洋学院海南热带海洋学院崖州湾创新研究院;琼台师范学院热带生物多样性与资源利用实验室【正文语种】中文【中图分类】S942.9【相关文献】1.泥鳅源霍乱弧菌的分离鉴定及药敏试验2.台湾泥鳅幼鱼红点病病原的分离鉴定及药敏分析3.大鳞副泥鳅腐皮病病原菌及其拮抗菌的分离筛选4.棘胸蛙腐皮病病原菌分离鉴定及五倍子水提液的治疗效果探究因版权原因,仅展示原文概要,查看原文内容请购买。
霍乱弧菌的分离与鉴定濮阳市疾病预防控制中心一、标本的采集和送检:1.标本的采集:1)粪便标本:应争取在发病早期、服用抗菌药物之前采集;2)采便方法:可用棉拭采取自然排出的新鲜大便,亦可用直肠棉拭采便管由肛门插入直肠内3~5厘米处采取。
3)采样要求:☞水样便采取1~2毫升,成形便采取指甲大小的粪量。
病人呕吐物、沾染粪便的衣物、尸体的肠腔和口腔内容物亦可作为检材。
☞外环境样本可采取病人的污染衣物、剩饭菜、可疑食品、抹布、污水、坑塘水、井水、公厕粪便、苍蝇等。
☞按1:10比例臵入碱性蛋白胨水增菌液中,迅速送往实验室。
4)肛拭采集的注意事项:1.棉拭子要用竹签,圆形、光滑以免采样时易断;2.棉拭子做的要稍大而紧固(避免采集时脱落);3.采集者应穿戴一次性手套;4.采集前将棉拭子用碱性蛋白胨水(APW)蘸湿,多余的液体紧靠管壁挤出;5.采集时要求被采集者双腿分立、微屈、手扶墙或凳子趴下,劝其用单手或双手协助分开股沟(或采集者用左手分开股沟),右手持棉拭子轻轻旋转插入肛门内约4~5cm(幼儿约2~3cm)处,转动数秒钟从紧靠肛环边的隐窝旋转擦取直肠表面黏液后退出;6.棉拭子在推进时如感觉遇到阻力,应调整角度后缓缓旋转推进,避免用力过大或推进太快造成肛壁出血而影响病原菌的检出;棉拭子进入的深度一定要够,否则采集的有效标本量会很少;7.采集的标本拭子应立即臵入APW内,手接触的部分在管口折断弃去。
填写采样登记表(单),并在采样管上填写被采集者的样品编号、姓名、性别、年龄,尽快送检。
二、快速诊断:1.直接镜检:为争取最快速度作出诊断,采取病人“米泔水样”大便或呕吐物,悬滴法镜检(最好用暗视野),可见具有流星状动力的细菌。
2.特异性制动试验:☞取检材或新鲜碱性蛋白胨水培养物一滴,臵于载玻片上,再加霍乱弧菌O1多价或O139诊断血清,加盖玻片,用暗视野显微镜观察,3分钟内流行状运动细菌被抑制的即为阳性,此法优点是快速而特异,操作简便,可☞在几分钟之内做出初步诊断。
但要求标本必须有较多数量的弧菌,免疫血清最好是不加防腐剂的。
3.早期玻片凝集试验:☞埃尔托弧菌在TCBS、4号琼脂及庆大霉素平皿上生长较快,37℃培养8~10小时,在其他杂菌尚未生长或长出很小菌落的情况下,埃尔托型菌落直径可达1~2mm。
将已长出较大半透明菌落或湿润菌苔的平皿取出,直接用霍乱多价血清做玻片凝集,阳性者可做初步报告。
琼脂平皿继续培养,接常规培养时间再作一次复查。
4.霍乱弧菌胶体金免疫层析快速检测:(1)原理:采用胶体金免疫层析双抗体夹心法,检测标本中霍乱弧菌。
以胶体金作为标记物,交联抗霍乱弧菌(O1群/O139群或O1群E1Tor型小川血清型、稻叶血清型)单克隆抗体,与样品中的霍乱弧菌(O1群/O139群)结合。
形成双抗体夹心一步法,呈现出目测可见的红色条带,显色程度与抗原含量成正比。
(2)特点:☞灵敏度高、特异性强,操作简便、快速,省力省时;☞对于典型霍乱病人水样或米泔样便结果准确、易于判读;☞但对于含霍乱弧菌少的粪便标本易出现假阴性;☞对脓血便标本易出现假阳性。
3)操作步骤:☞将检测卡放臵与洁净、干燥的工作台上;☞实验前,请将试剂恢复至室温;☞用吸管取病人水样便样品2~3滴,加入检测卡一端的加样孔,计时并观察反应结果;☞2-15分钟内观察结果,20分钟之后结果不能判读。
(1) 滤样纸(加样区);(2) 玻璃纤维膜,膜上吸附着干燥的金标抗原;(3) 硝酸纤维素膜,膜上包被的抗原和抗体呈线状;(4) 吸水纸。
三、直接分离、培养:☞急性期病人水样大便标本在增菌培养的同时可用选择性培养基直接划线分离。
目前常用的强选择性培养基有TCBS琼脂、4号琼脂和庆大霉素琼脂等。
☞臵37℃10~14h孵育培养。
四、APW增菌、分离:☞所有粪便标本都应经过增菌,尤其是恢复期病人,带菌者或用过抗菌药物的病人标本含菌量少,单靠直接分离不易检出,需经碱胨水37℃增菌6~8小时后分离(夏日可将运送时间计算在内);☞标本含菌量少时,为提高检出率可实行2次增菌,取第一次碱胨水增菌后的培养物表层液0.1~0.2毫升,接种于8~10毫升的碱胨水中,37℃培养6~8小时后再做分离;☞霍乱弧菌好氧,易形成的菌膜,故在取出增菌管时动作要轻,接种环于菌膜下取一满环,划线接种于TCBS或4号琼脂平板37℃10~14h孵育培养。
五、血清学凝集试验:1.玻片凝集试验:☞自分离培养基上挑取可疑菌落与O1群霍乱多价诊断血清、O139群霍乱诊断血清以及稻叶、小川型诊断血清做玻片凝集试验;☞同时注意做盐水凝集对照试验。
2.要求及注意事项:☞有的标本可能同时存在非O1群霍乱弧菌,可疑菌落较多时,应挑选5个以上的菌落逐个进行玻片凝集检查;☞必要时,取原划线菌苔边缘透明部分再做玻片凝集(对一次流行的首批病人进行检验时尤应注意)。
☞平皿分离未获分散的单个菌落,而在密集部位仍有可疑菌落时,应将该部分再做分离或经增菌后再做分离;☞从恢复期病人分离出菌落典型但不凝集的弧菌,这时应以霍乱粗糙型血清做玻片凝集,以确定是否为粗糙型或NAG弧菌;☞注意当霍乱弧菌在4号及庆大霉素培养基上生长过久(超过36小时)时,会出现菌落粘稠、血清凝集假阴性现象;☞故应取新鲜培养物(10~14h)作凝集试验,凝集的菌落立即转种营养琼脂平板。
☞小川型菌株有时在稻叶型单价血清中可出现弱凝集,这并非彦岛型,而是小川型含有少量C抗原成分的缘故;☞首例病人应以两个单价血清的试管凝集试验确定。
六、初步鉴定试验:1.氧化酶试验:在非选择性或非鉴别性培养基如营养琼脂的新鲜培养物上滴加氧化酶试剂1滴,并使其流开。
或将菌落用竹签或牙签挑至滴有试剂的滤纸上,在1分钟内出现粉红-紫红-紫蓝色(有的最后呈黑紫色)为氧化酶阳性。
(肠杆菌科细菌多不变色或变成粉红色后很快退色为氧化酶阴性)。
氧化酶试验注意事项:试验时避开含铁物质(如接种环)。
不能直接取产酸培养基上的菌落,不能取含还原剂的培基及含亚碲酸盐培基上的菌落(亚碲酸盐培养基可抑制氧化酶),以免出现假阳性和假阴性。
2.拉丝试验:在玻片上加一滴试剂,取一接种环被检菌的新鲜琼脂培养物在试剂旁边研磨均匀,再与试剂混合制成浓厚悬液。
阳性者很快(30S内)由混变清并变得很粘稠,用接种环挑取时,可以拉出细丝来。
阴性者呈均匀悬液状态,与蒸馏水对照相同。
(古典型、埃尔托型和O139群霍乱弧菌均阳性。
)弧菌科菌属氧化酶试验、拉丝试验鉴别表3.O/129(二氨基二异丙基喋啶)敏感试验:☞用接种环或灭菌棉拭子在含0.5%氯化钠的普通平皿上均匀涂抹待检菌,放上10µg、150µgO/129磷酸盐药敏纸片各一片,37℃培养过夜。
凡药敏纸片周围出现抑菌圈者为敏感。
☞古典型、埃尔托型霍乱弧菌二者均敏感;☞O139群霍乱弧菌10µg、150µg均不敏感。
七、初步结果报告:霍乱弧菌以血清学鉴定为主,结合菌落形态、特征和初步生化反应可做出判定。
凡具备弧菌菌落特征、与O1群或O139群多价血清凝集,O1群并可用单价血清分型即可判定。
首例病人应辅以氧化酶、拉丝试验、O/129敏感试验。
基层CDC 至此即可上报。
上报国家需做生化、噬菌体-生物分型试验。
报告名称--“稻叶/小川型O1群埃尔托型霍乱弧菌”或“O139群埃尔托型霍乱弧菌”。
八、生化鉴定试验:九、噬菌体-生物分型:1. 古典型和Eltor分型:☞目前仍依靠第IV组霍乱噬菌体常规稀释液(106/毫升)裂解试验、多粘菌素B敏感试验、鸡血球凝集、V-P和溶血试验进行两种生物型的鉴别仅作参考。
埃尔托型已出现大量非溶血菌株,因此溶血试验已不能作为区别两个生物型的主要方法。
O1群霍乱弧菌古典型和El-Tor生物型的鉴别(1)噬菌体分型:☞根据五株国内分离的5种弧菌噬菌体 (VP1~VP5)将埃尔托型霍乱弧菌分成32个噬菌体型 (见下表)。
方法:利用双层琼脂平皿法进行噬菌体滴皿裂解试验。
(2)生物分型:☞根据菌株的溶原性、对溶原噬菌体的敏感性、山梨醇发酵试验和溶血试验等四个生物学性状,将埃尔托弧菌分成12个生物型。
埃尔托霍乱生物分型表埃尔托霍乱弧菌噬菌体-生物分型表十、O1群与O139群霍乱弧菌的鉴别:十一、霍乱菌种的登记、保存、上送和管理:1.霍乱菌株的登记:基层实验室所检获的阳性菌种及可疑菌种,均应作好菌株来源详细情况的登记工作,包括编号、被检人或物名称、菌株来源(病人、带菌者或外环境)、分离地点(地址)及初步鉴定结果(见省CDC “河南省霍乱监测方案”附表),一式两份,一份自己保存,一份随菌种上送。
2.霍乱种株的保存:对初步鉴定的霍乱弧菌及可疑菌株(包括不凝集弧菌),均应接种半固体菌种管培养基,经37℃过夜培养,用胶塞或石蜡封口,室温保存,切勿放入冰箱,因霍乱菌种半固体的最佳保存环境是18~25℃(一般可存活4~5年)。
☠霍乱弧菌在4 ℃~8℃以下极易死亡。
3.霍乱种株的上送:菌、毒种的上送工作是程序,也是制度。
按照《中华人民共和国传染病防治法》、卫生部规定:各疫点市(县)在本年度疫情结束后必须立即收集整理当地分离到的所有霍乱菌株和可疑菌株,认真登记、造册,连同菌种一并派专人(2人)护送上级市(地)CDC;市(地)防疫站收集、整理所辖市、县上送菌种后,再届时按毒菌种管理规定上送省CDC,最后由省CDC统一进行编号、登记、整理备案,并进行血清学、生化学及噬菌体-生物分型鉴定、药物敏感性测定后上报国家CDC和卫生部。
4.霍乱种株的管理:相关法规:《中华人民共和国传染病防治法实施办法》和卫生部菌种管理委员会制定的《中国医学微生物菌种保藏管理办法》。
菌(毒)种的保藏由国务院卫生行政部门指定的单位负责。
一、二类菌(毒)种的供应由国务院卫生行政部门指定的保藏管理单位供应。
三类菌(毒)种由设有专业实验室的单位或者国务院卫生行政部门指定的保藏管理单位供应。
认真做好登记,统一编号,冻干保存,按期传代、鉴定,并作好有关检验记录。
在保存过程中发生菌、毒种变异或死亡,应及时上报科主任及主管部门。
当地所检出的地方菌、毒株应及时上报,因工作需要暂时保留的菌、毒株也应按上级规定的时间进行销毁处理。
新发现的菌、毒种,要做好原始记录,一并上报主管部门复核确认。
使用一类菌(毒)种的单位,必须经国务院卫生行政部门批准;使用二类菌(毒)种的单位必须经省级政府卫生行政部门批准;使用三类菌(毒)种的单位,应当经县级政府卫生行政部门批准。
一、二类菌(毒)种,应派专人向供应单位领取,不得邮寄;三类菌(毒)种的邮寄必须持有邮寄单位的证明,并按照菌(毒)种邮寄与包装的有关规定办理。
未经上级主管部门批准,任何单位及个人不得以工作之便,进行国际间各类菌、毒种交流。